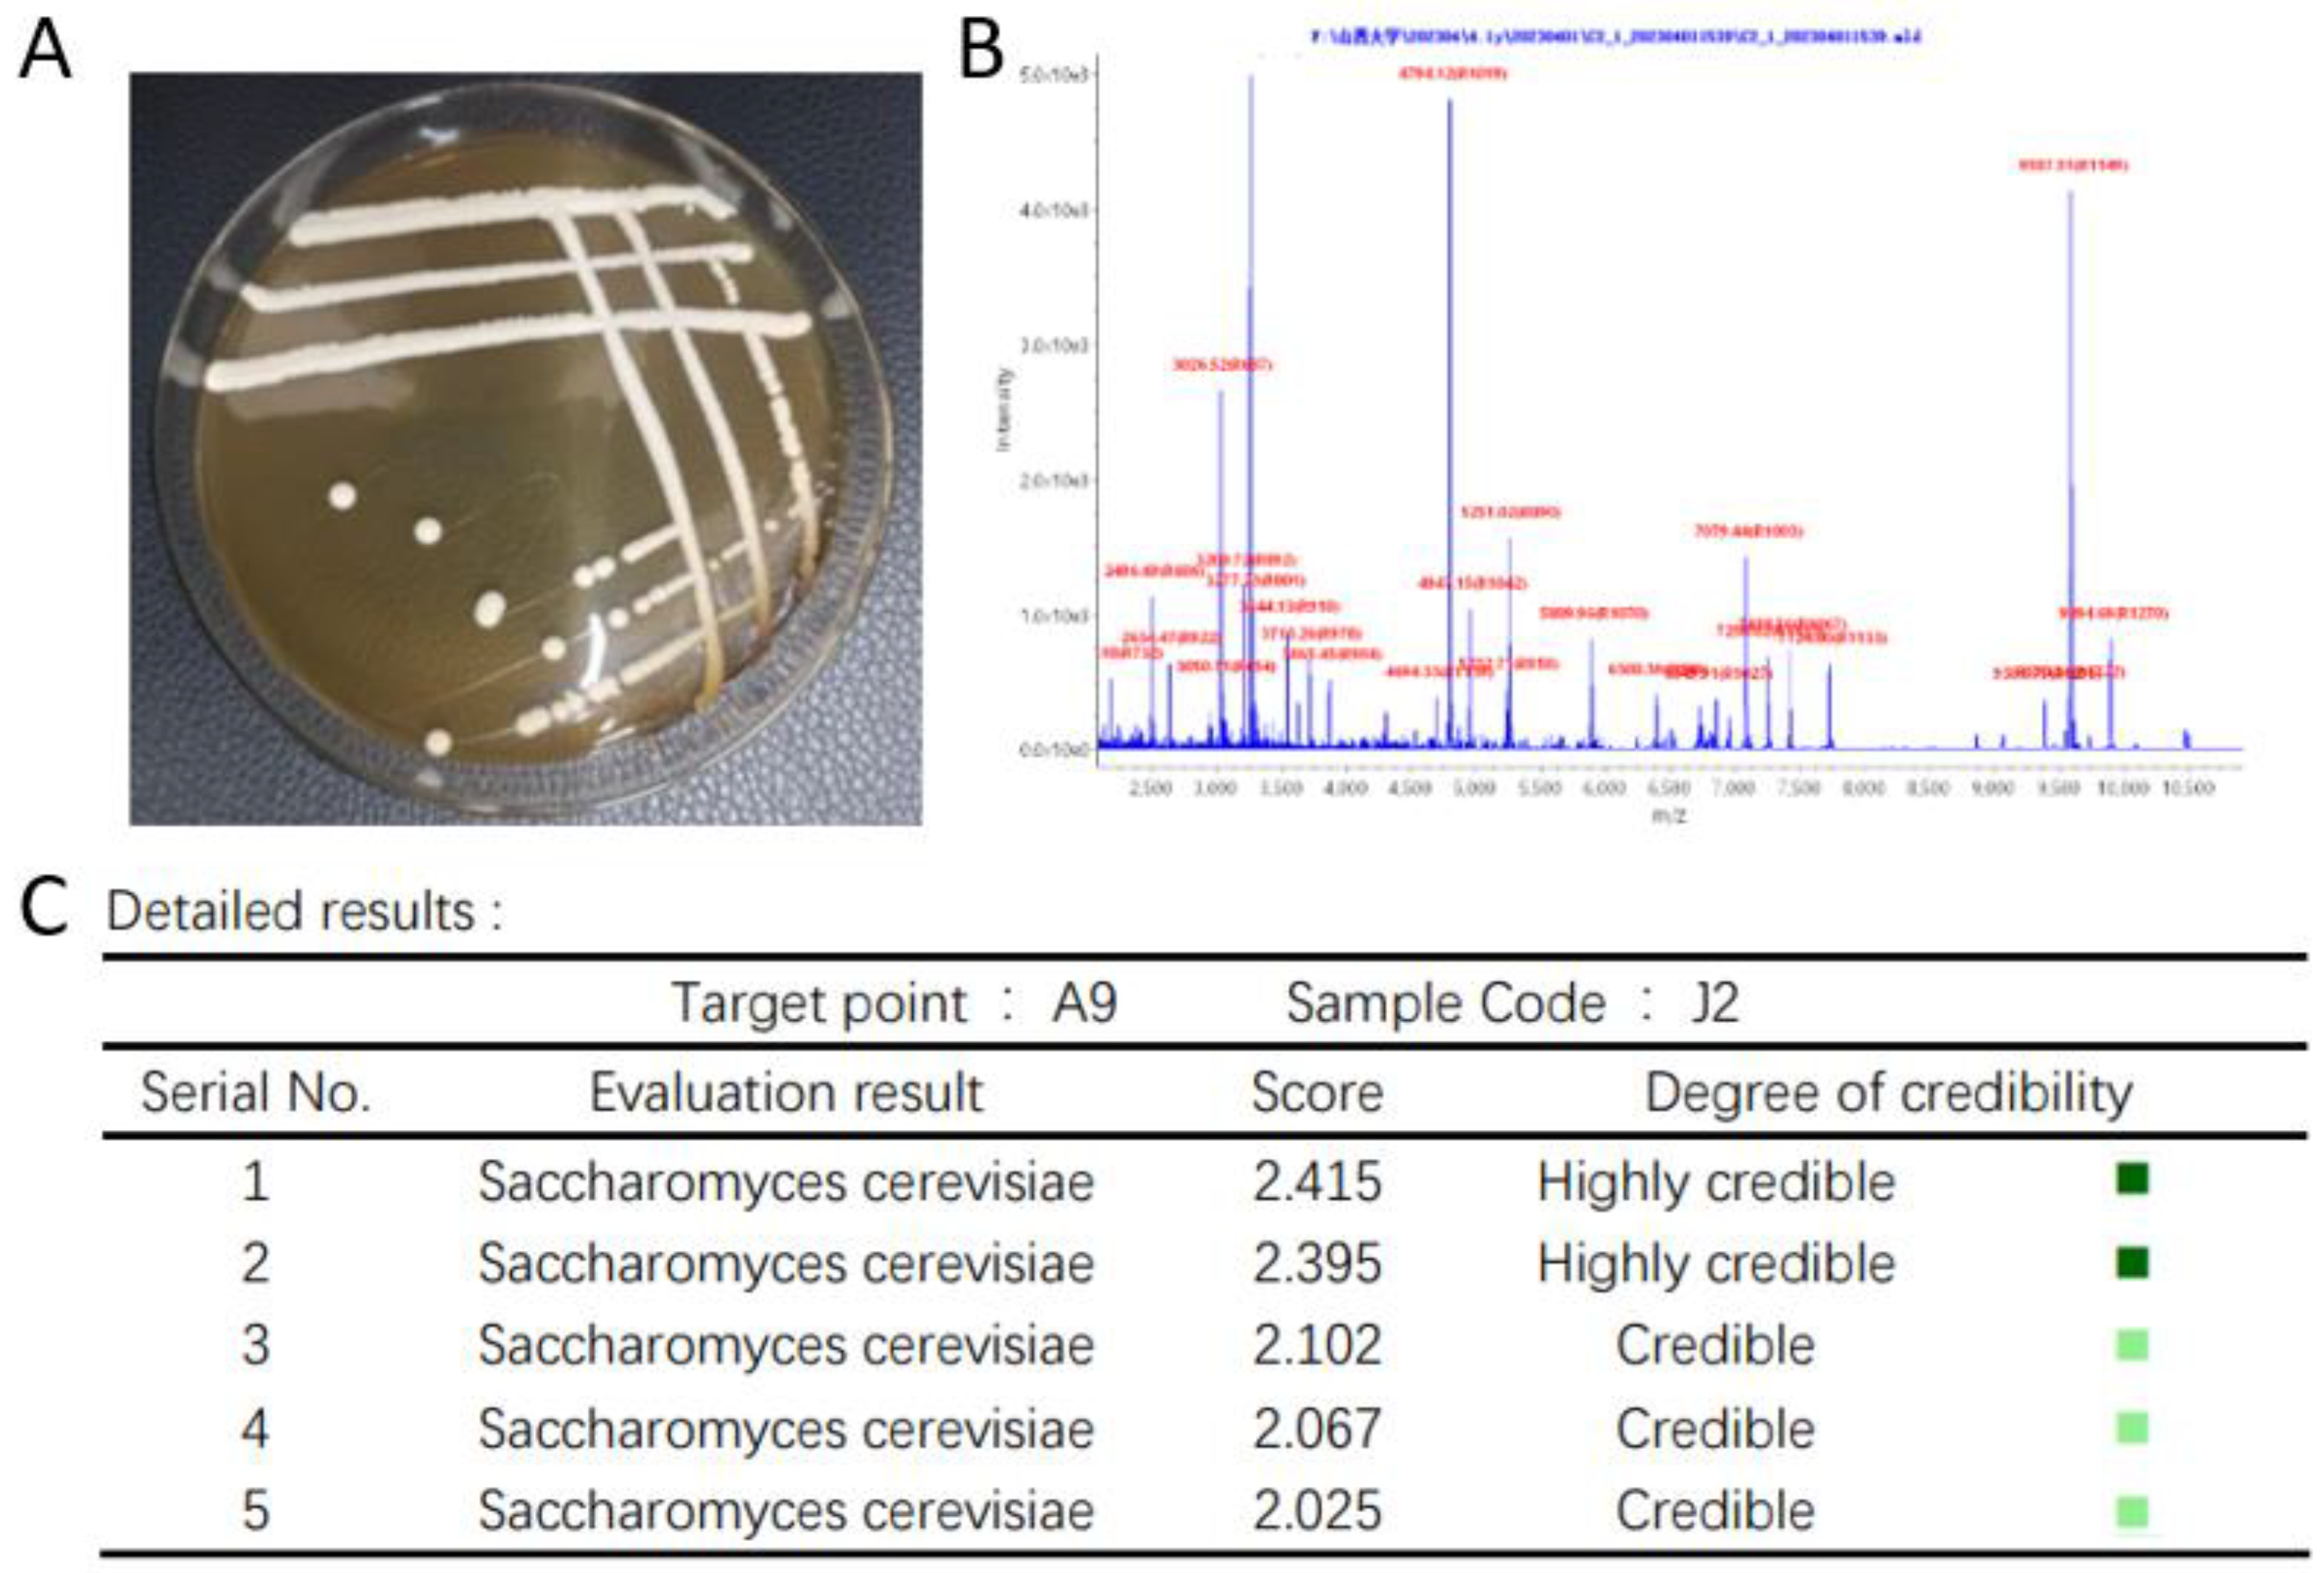
Fermentation 10 00484 g003

Germplasm Resource Mining of Fen-Flavor Baijiu Brewing Micro-Organisms and Screening of Important Functional Strains
Abstract
1. Introduction
2. Materials and Method
2.1. Reagents and Materials
2.2. Instruments and Equipment
2.3. Experimental Methods
2.3.1. Setting of Cultivation Conditions
2.3.2. Isolation and Purification of Fermented Grains Strains
2.3.3. Screening of Functional Strains
2.3.4. Study on the Tolerance of Strains
2.4. Morphological Identification of Strains and MALDI-TOF-MS Identification
2.5. Molecular Biology Analysis of Strains
2.6. Strain Conservation
3. Result and Analysis
3.1. Results of Fungal Isolation
3.2. Results of Bacterial Isolation
3.3. Screening Results of Functional Strains
3.3.1. Screening and Characterization of Ethyl Acetate-Producing Yeasts
Screening for High-Yielding Ethyl Acetate Yeasts
Studies on the Tolerance of High-Yielding Ethyl Acetate Yeasts
Colony Morphology and MALDI-TOF-MS Identification of High-Yield Ethyl Acetate Yeast
Molecular Biological Validation of High-Yielding Ethyl Acetate Yeasts
3.3.2. Screening and Characterization of Lactic Acid Degrading Bacteria
Screening of Lactic Acid Degrading Bacteria
Tolerance Studies of Lactic Acid Degrading Bacteria
Colony Morphology and MALDI-TOF-MS Identification of Lactic Acid Degrading Bacteria
Molecular Biological Validation of Lactic Acid Degrading Bacteria
4. Conclusions and Discussion
Author Contributions
Funding
Institutional Review Board Statement
Informed Consent Statement
Data Availability Statement
Acknowledgments
Conflicts of Interest
References
- Zheng, X.-W.; Yan, Z.; Han, B.-Z.; Zwietering, M.H.; Samson, R.A.; Boekhout, T.; Nout, M.J.R. Complex microbiota of a Chinese “Fen” liquor fermentation starter (Fen-Daqu), revealed by culture-dependent and culture-independent methods. Food Microbiol. 2012, 31, 293–300. [Google Scholar] [CrossRef] [PubMed]
- Wang, H.Y.; Gao, Y.B.; Fan, Q.W.; Xu, Y. Characterization and comparison of microbial community of different typical Chinese liquor Daqus by PCR-DGGE. Lett. Appl. Microbiol. 2011, 53, 134–140. [Google Scholar] [CrossRef] [PubMed]
- Zheng, X.-W.; Yan, Z.; Nout, M.J.R.; Smid, E.J.; Zwietering, M.H.; Boekhout, T.; Han, J.-S.; Han, B.-Z. Microbiota dynamics related to environmental conditions during the fermentative production of Fen-Daqu, a Chinese industrial fermentation starter. Int. J. Food Microbiol. 2014, 182–183, 57–62. [Google Scholar] [CrossRef]
- Wang, X.; Du, H.; Xu, Y. Source tracking of prokaryotic communities in fermented grain of Chinese strong-flavor liquor. Int. J. Food Microbiol. 2017, 244, 27–35. [Google Scholar] [CrossRef] [PubMed]
- Yan, Q.; Zhang, K.; Zou, W.; Hou, Y. Three main flavour types of Chinese Baijiu: Characteristics, research, and perspectives. J. Inst. Brew. 2021, 127, 317–326. [Google Scholar] [CrossRef]
- Niu, Y.; Yao, Z.; Xiao, Q.; Xiao, Z.; Ma, N.; Zhu, J. Characterization of the key aroma compounds in different light aroma type Chinese liquors by GC-olfactometry, GC-FPD, quantitative measurements, and aroma recombination. Food Chem. 2017, 233, 204–215. [Google Scholar] [CrossRef]
- Fan, G.; Sun, B.; Xu, D.; Teng, C.; Fu, Z.; Du, Y.; Li, X. Isolation and Identification of High-Yield Ethyl Acetate-Producing Yeast from Gujinggong Daqu and Its Fermentation Characteristics. J. Am. Soc. Brew. Chem. 2018, 76, 117–124. [Google Scholar] [CrossRef]
- Ren, J.-Y.; Liu, G.; Chen, Y.-F.; Jiang, S.; Ma, Y.-R.; Zheng, P.; Guo, X.-W.; Xiao, D.-G. Enhanced Production of Ethyl Lactate in Saccharomyces cerevisiae by Genetic Modification. J. Agric. Food Chem. 2020, 68, 13863–13870. [Google Scholar] [CrossRef]
- Du, S.; Yao, L.; Zhong, B.; Qin, J.; He, S.; Liu, Y.; Wu, Z. Enhancing synthesis of ethyl lactate in rice baijiu fermentation by adding recovered granular cells. J. Biosci. Bioeng. 2024, 137, 388–395. [Google Scholar] [CrossRef]
- Li, X.; Zhang, X.; Jian, H.; Xu, X.; Xi, Y. Biocycle Fermentation Based on Lactic Acid Bacteria and Yeast for the Production of Natural Ethyl Lactate. ACS Omega 2019, 4, 16009–16015. [Google Scholar] [CrossRef]
- Lagier, J.-C.; Dubourg, G.; Million, M.; Cadoret, F.; Bilen, M.; Fenollar, F.; Levasseur, A.; Rolain, J.-M.; Fournier, P.-E.; Raoult, D. Culturing the human microbiota and culturomics. Nat. Rev. Microbiol. 2018, 16, 540–550. [Google Scholar] [CrossRef] [PubMed]
- Fournier, P.-E.; Lagier, J.-C.; Dubourg, G.; Raoult, D. From culturomics to taxonomogenomics: A need to change the taxonomy of prokaryotes in clinical microbiology. Anaerobe 2015, 36, 73–78. [Google Scholar] [CrossRef] [PubMed]
- Naud, S.; Khelaifia, S.; Mbogning Fonkou, M.D.; Dione, N.; Lagier, J.C.; Raoult, D. Proof of Concept of Culturomics Use of Time of Care. Front. Cell. Infect. Microbiol. 2020, 10, 524769. [Google Scholar] [CrossRef] [PubMed]
- Schwake, D.O.; Sandrin, T.; Zhang, L.; Abbaszadegan, M. Strain-Level Characterization of Legionella Environmental Isolates via MALDI-TOF-MS. Microorganisms 2022, 11, 8. [Google Scholar] [CrossRef] [PubMed]
- Huan, W.; Yongguang, H.; Yunli, H. Microbiome diversity and evolution in stacking fermentation during different rounds of Jiang-flavoured Baijiu brewing. LWT 2021, 143, 111119. [Google Scholar]
- Urso, R.; Rantsiou, K.; Dolci, P.; Rolle, L.; Comi, G.; Cocolin, L. Yeast biodiversity and dynamics during sweet wine production as determined by molecular methods. FEMS Yeast Res. 2008, 8, 1053–1062. [Google Scholar] [CrossRef]
- Cristian, V. The impact of non-Saccharomyces yeasts in the production of alcoholic beverages. Appl. Microbiol. Biotechnol. 2016, 100, 9861–9874. [Google Scholar]
- Li, R.-R.; Xu, M.; Zheng, J.; Liu, Y.-J.; Sun, C.-H.; Wang, H.; Guo, X.-W.; Xiao, D.-G.; Wu, X.-L.; Chen, Y.-F. Application Potential of Baijiu Non-Saccharomyces Yeast in Winemaking Through Sequential Fermentation With Saccharomyces cerevisiae. Front. Microbiol. 2022, 13, 902597. [Google Scholar] [CrossRef]
- Nan, D.; Hai, D.; Yan, X. Cooperative Response of Pichia kudriavzevii and Saccharomyces cerevisiae to Lactic Acid Stress in Baijiu Fermentation. J. Agric. Food Chem. 2020, 68, 4903–4911. [Google Scholar]
- Liu, S.; Yang, L.; Zhou, Y.; He, S.; Li, J.; Sun, H.; Yao, S.; Xu, S. Effect of mixed moulds starters on volatile flavor compounds in rice wine. LWT 2019, 112, 108215. [Google Scholar] [CrossRef]
- Wu, X.; Jiang, Q.; Wang, Z.; Xu, Y.; Chen, W.; Sun, J.; Liu, Y. Diversity, enzyme production and antibacterial activity of Bacillus strains isolated from sesame-flavored liquor Daqu. Arch. Microbiol. 2021, 203, 5831–5839. [Google Scholar] [CrossRef] [PubMed]
- Chen, C.; Xiong, Y.; Xie, Y.; Zhang, H.; Jiang, K.; Pang, X.N.; Huang, M. Metabolic characteristics of lactic acid bacteria and interaction with yeast isolated from light-flavor Baijiu fermentation. Food Biosci. 2022, 50, 102102. [Google Scholar] [CrossRef]
- Jiang, F.-G.; Cheng, H.-J.; Liu, D.; Wei, C.; An, W.-J.; Wang, Y.-F.; Sun, H.-T.; Song, E.-L. Treatment of Whole-Plant Corn Silage with Lactic Acid Bacteria and Organic Acid Enhances Quality by Elevating Acid Content, Reducing pH, and Inhibiting Undesirable Microorganisms. Front. Microbiol. 2020, 11, 593088. [Google Scholar] [CrossRef] [PubMed]
- Heredia-Castro, P.Y.; Méndez-Romero, J.I.; Hernández-Mendoza, A.; Acedo-Félix, E.; González-Córdova, A.F.; Vallejo-Cordoba, B. Antimicrobial activity and partial characterization of bacteriocin-like inhibitory substances produced by Lactobacillus spp. isolated from artisanal Mexican cheese. J. Dairy Sci. 2015, 98, 8285–8293. [Google Scholar] [CrossRef] [PubMed]
- Harbige, L.S.; Pinto, E.; Allgrove, J.; Thomas, L.V. Immune Response of Healthy Adults to the Ingested Probiotic Lactobacillus casei Shirota. Scand. J. Immunol. 2016, 84, 353–364. [Google Scholar] [CrossRef]
- Wanderley Porto, M.C.; de Souza de Azevedo, P.O.; Lourenço, F.R.; Converti, A.; Vitolo, M.; de Souza Oliveira, R.P. Effect of Polydextrose on the Growth of Pediococcus pentosaceus as Well as Lactic Acid and Bacteriocin-like Inhibitory Substances (BLIS) Production. Microorganisms 2022, 10, 1898. [Google Scholar] [CrossRef]
- Tong, S.Y.C.; Davis, J.S.; Eichenberger, E.; Holland, T.L.; Fowler, V.G., Jr. Staphylococcus aureus infections: Epidemiology, pathophysiology, clinical manifestations, and management. Clin. Microbiol. Rev. 2015, 28, 603–661. [Google Scholar] [CrossRef]
- Kang, J.; Sun, Y.; Huang, X.; Ye, L.; Chen, Y.; Chen, X.; Zheng, X.; Han, B.-Z. Unraveling the microbial compositions, metabolic functions, and antibacterial properties of Huangshui, a byproduct of Baijiu fermentation. Food Res. Int. 2022, 157, 111320. [Google Scholar] [CrossRef]
- Michael, O. Molecular basis of Staphylococcus epidermidis infections. Semin. Immunopathol. 2012, 34, 201–214. [Google Scholar]
- Huang, S.; Liu, T.; Peng, B.; Geng, A. Enhanced ethanol production from industrial lignocellulose hydrolysates by a hydrolysate-cofermenting Saccharomyces cerevisiae strain. Bioprocess. Biosyst. Eng. 2019, 42, 883–896. [Google Scholar] [CrossRef]
- Liu, J.; Zhu, Y.; Du, G.; Zhou, J.; Chen, J. Exogenous ergosterol protects Saccharomyces cerevisiae from D-limonene stress. J. Appl. Microbiol. 2013, 114, 482–491. [Google Scholar] [CrossRef] [PubMed]
- Fumio, M.; Chikara, F.; Takashi, K.; Jun, I. Engineering strategy of yeast metabolism for higher alcohol production. Microb. Cell Factories 2011, 10, 70. [Google Scholar]
- Wei, J.; Nie, Y.; Du, H.; Xu, Y. Reduced lactic acid strengthens microbial community stability and function during Jiang-flavour Baijiu fermentation. Food Biosci. 2024, 59, 103935. [Google Scholar] [CrossRef]

| Serial No. | Culture Medium | Oxygen Conditions | Temperature | Additional Reagents |
|---|---|---|---|---|
| B1 | MRS medium | Aerobic | 37 °C | |
| B2 | LB medium | Aerobic | 37 °C | |
| B3 | R2A medium | Aerobic | 37 °C | |
| B4 | Gao’s No. 1 medium | Aerobic | 37 °C | |
| B5 | Original medium | Aerobic | 37 °C | |
| F1 | YPD medium | Aerobic | 28 °C | 0.1 g/L chloramphenicol |
| F2 | PDA medium | Aerobic | 28 °C | 0.1 g/L chloramphenicol |
| F3 | DG18 medium | Aerobic | 28 °C | 0.1 g/L chloramphenicol |
| F4 | Rose Bengal medium | Aerobic | 28 °C | 0.1 g/L chloramphenicol |
| F5 | Original medium | Aerobic | 28 °C | 0.1 g/L chloramphenicol |
| Serial No. | Strain Name | Cultivation Conditions | Score Range | Number of Isolates |
|---|---|---|---|---|
| 1 | Saccharomyces cerevisiae | F1, F2, F3, F4, F5 | 2.299~2.998 | 119 |
| 2 | Pichia kudriavzevii | F1, F2, F5 | 2.299~2.752 | 29 |
| 3 | Pichia fermentans | F4, F5 | 2.299~2.681 | 3 |
| 4 | Candida parapsilosis | F1, F4 | 2.299~2.719 | 5 |
| 5 | Candida albicans | F1, F2, F5 | 2.299~2.669 | 5 |
| 6 | Candida orthopsilosis | F2, F3 | 2.299~2.492 | 2 |
| 7 | Penicillium oxalicum | F3, F2 | 1.999~2.448 | 4 |
| 8 | Aspergillus fumigatus | F1, F4 | 2.299~2.394 | 4 |
| 9 | Candida pelliculosa | B3 | 2.011~2.360 | 1 |
| 10 | Candida lusitaniae | B2, B3 | 2.047~2.251 | 2 |
| 11 | Fusarium oxysporum | B4 | 2.044~2.359 | 1 |
| 12 | Fusarium solani | B3 | 2.102~2.315 | 1 |
| 13 | Talaromyces marneffei | B3 | 2.141~2.622 | 1 |
| Serial No. | Strain Name | Cultivation Conditions | Score Range | Number of Isolates |
|---|---|---|---|---|
| 1 | Bacillus licheniformis | B1, B2, B3, B4, B5 | 2.299~2.994 | 76 |
| 2 | Bacillus simplex | B2 | 2.128~2.274 | 1 |
| 3 | Bacillus subtilis | B1, B2, B3 | 2.061~2.847 | 7 |
| 4 | Bacillus pumilus | B3, B4, B5 | 2.069~2.531 | 5 |
| 5 | Bacillus cereus | B2 | 2.037~2.497 | 2 |
| 6 | Bacillus amyloliquefaciens | B1, B2 | 2.007~2.633 | 3 |
| 7 | Lactobacillus plantarum | B1, B3 | 2.190~2.839 | 4 |
| 8 | Lactobacillus brevis | B1, B2, B3 | 2.097~2.831 | 6 |
| 9 | Lactobacillus paracasei | B2 | 2.197~2.417 | 1 |
| 10 | Lactobacillus beijerinck | B1 | 2.367~2.427 | 1 |
| 11 | Lactobacillus fermentum | B5 | 2.191~2.652 | 1 |
| 12 | Pediococcus pentosaceus | B1, B2, B3 | 2.062~2.573 | 3 |
| 13 | Staphylococcus aureus | B1, B2, B4 | 2.102~2.850 | 5 |
| 14 | Staphylococcus epidermidis | B1, B3, B4, B5 | 1.999~2.738 | 20 |
| 15 | Staphylococcus xylosus | B1, B2 | 2.116~2.695 | 2 |
| 16 | Moraxella osloensis | B3 | 1.999~2.315 | 1 |
| 17 | Actinomyces meyeri | B4 | 2.052~2.530 | 1 |
| 18 | Stenotrophomonas maltophilia | B3, B4, B5 | 2.141~2.622 | 9 |
| Yeast Name | Ethyl Acetate Content (g/L) |
|---|---|
| J2 | 1.198 ± 0.36 |
| J3 | 0.014 ± 0.14 |
| J6 | 1.701 ± 0.11 |
| J11 | 0.641 ± 0.05 |
| J12 | 0.022 ± 0.67 |
| J14 | 0.575 ± 0.24 |
| J17 | 0.0075 ± 1.31 |
| J20 | 0.0029 ± 0.74 |
| J23 | 0.0082 ± 2.17 |
Disclaimer/Publisher’s Note: The statements, opinions and data contained in all publications are solely those of the individual author(s) and contributor(s) and not of MDPI and/or the editor(s). MDPI and/or the editor(s) disclaim responsibility for any injury to people or property resulting from any ideas, methods, instructions or products referred to in the content. |
© 2024 by the authors. Licensee MDPI, Basel, Switzerland. This article is an open access article distributed under the terms and conditions of the Creative Commons Attribution (CC BY) license (https://creativecommons.org/licenses/by/4.0/).
Share and Cite
Zhang, J.; Zhang, T.; Hou, Z.; Dang, L.; Chen, M.; Bai, B.; Yang, Y.; Fan, S.; Bo, T. Germplasm Resource Mining of Fen-Flavor Baijiu Brewing Micro-Organisms and Screening of Important Functional Strains. Fermentation 2024, 10, 484. https://doi.org/10.3390/fermentation10090484
Zhang J, Zhang T, Hou Z, Dang L, Chen M, Bai B, Yang Y, Fan S, Bo T. Germplasm Resource Mining of Fen-Flavor Baijiu Brewing Micro-Organisms and Screening of Important Functional Strains. Fermentation. 2024; 10(9):484. https://doi.org/10.3390/fermentation10090484
Chicago/Turabian StyleZhang, Jinhua, Tianyang Zhang, Zhixing Hou, Ling Dang, Min Chen, Baoqing Bai, Yukun Yang, Sanhong Fan, and Tao Bo. 2024. "Germplasm Resource Mining of Fen-Flavor Baijiu Brewing Micro-Organisms and Screening of Important Functional Strains" Fermentation 10, no. 9: 484. https://doi.org/10.3390/fermentation10090484
APA StyleZhang, J., Zhang, T., Hou, Z., Dang, L., Chen, M., Bai, B., Yang, Y., Fan, S., & Bo, T. (2024). Germplasm Resource Mining of Fen-Flavor Baijiu Brewing Micro-Organisms and Screening of Important Functional Strains. Fermentation, 10(9), 484. https://doi.org/10.3390/fermentation10090484






